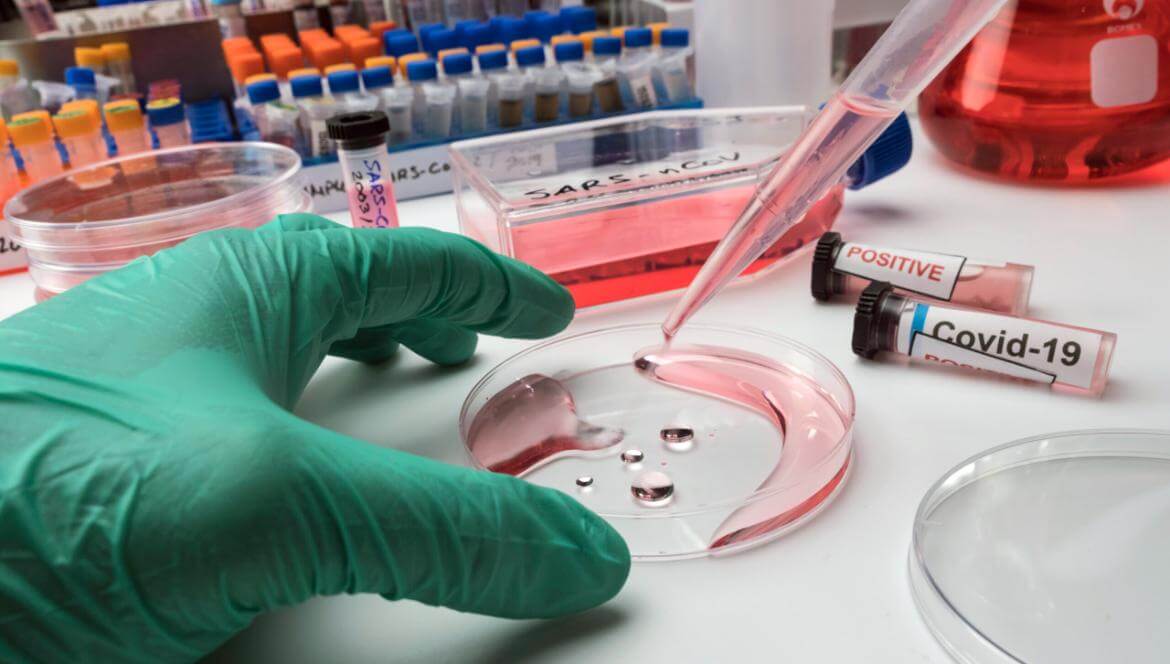
What is a Biopsy?

What is a Biopsy?
A biopsy is a diagnostic procedure that involves surgically removing cells, fluid, or tissue from a suspected disease site. It is used to definitively diagnose various diseases, particularly cancer. Biopsies are performed by analyzing small tissue, cell, or fluid samples in pathology laboratories, and are then analyzed and reported by pathologists. This method is crucial for identifying diseased tissue, detecting abnormalities, and establishing a definitive diagnosis necessary for appropriate treatment.
Over the years, advances in technology have enabled biopsy to yield faster and more accurate results. This method allows for the examination of tissue suspected of disease and is an important tool for pathologists in determining the nature of the disease. Pathological examination results play a critical role in determining the treatment plan.
Biopsy may not be solely a diagnostic method; in some cases, the entire biopsied tissue may be removed. In this case, the biopsy goes beyond mere diagnosis and serves as a treatment method. Removing the entire tissue may be necessary to halt or treat the progression of some cancers or major tissue changes.
How is a Biopsy Performed?
A biopsy is generally a safe procedure when performed by a qualified physician under appropriate conditions. The method of performing the biopsy varies depending on the area and purpose of the procedure. Some biopsies are performed with imaging guidance, others during or after surgery, and still others under local anesthesia.
The biopsy procedure generally includes the following steps:
- Patient preparation: Before the biopsy, the patient is appropriately prepared for the area to be treated. If necessary, specific steps, such as the use of blood-thinning medications, are discussed with the physician beforehand.
- Local anesthesia: The area to be treated is usually numbed with local anesthesia. This ensures that the patient feels no pain during the procedure.
- Biopsy method: A biopsy can be performed using various methods, depending on the area to be treated. In some cases, it is performed with the help of imaging methods such as ultrasound, X-ray, or MRI, while in other cases, it can be performed during or after surgery.
- Obtaining a tissue or fluid sample: The procedure continues with obtaining a tissue or fluid sample. The physician uses appropriate equipment to obtain a sample from the suspected area.
- Sending samples to the laboratory: Tissue or fluid samples are sent to the pathology laboratory for analysis. Pathologists examine the samples under a microscope to reach a diagnosis.
Each type of biopsy can be performed in a specific way, and the procedure itself is determined by the needs of your doctor and the area being treated. A biopsy procedure is generally carefully planned and implemented to ensure the patient's comfort and safety.
Why Is a Biopsy Done?
A biopsy is a medical procedure performed to determine whether an abnormal mass, lesion, or tissue in the body is cancerous. This procedure plays a crucial role in confirming a cancer diagnosis. A biopsy may also be performed for the following purposes:
- Cancer diagnosis: This is done to determine whether abnormal tissue detected through examination or imaging is cancerous. Tissue samples examined in the pathology laboratory reveal the presence or absence of cancer cells.
- Cancer type and characteristics: A biopsy determines the type and characteristics of the cancer, providing important information about how the disease is progressing and which treatment options are appropriate. This helps in developing a treatment plan and assessing the patient's health.
- Treatment and monitoring: Biopsy results help determine the stage and extent of cancer spread, helping determine the most appropriate treatment options. They are also used to monitor treatment effectiveness and determine necessary interventions if the disease progresses.
- Spread of disease: This is used to determine whether cancer cells have spread to other parts of the body. This plays an important role in staging the cancer and determining its progression.
A biopsy is an important step in making an accurate diagnosis and determining the appropriate treatment plan. Its results play a key role in determining the course of the disease and assessing response to treatment.
What Should Be Considered Before a Biopsy?
Points to consider before a biopsy may vary depending on the type of biopsy and the organ being examined. In general, some points to consider before a biopsy include:
- Blood-thinning medications: Blood-thinning medications should be adjusted according to your doctor's instructions before the biopsy. These medications can increase the risk of bleeding. Taking them as directed by your doctor may improve your condition before the biopsy.
- Fasting: You may be asked to fast for a certain period of time before the biopsy. This period should be as recommended by your doctor. You should consult your doctor regarding the required fasting period for the procedure.
- Blood tests: Blood tests are performed before the biopsy to assess blood clotting and bleeding tendency. These tests can be important in determining your suitability for the procedure.
- Reporting special circumstances: Any special circumstances, such as allergies , medications taken, pregnancy, or suspected pregnancy, should be shared with your doctor. Pregnancy, in particular, should be reported to your doctor due to the potential risks of radiation.
- Imaging methods: Some biopsies are performed with the help of imaging methods such as ultrasound, MRI, or CT scan. In these cases, appropriate preparation for these imaging methods can be made before the procedure.
Because every patient and biopsy type is different, it's important to follow your doctor's recommendations. Following your doctor's instructions beforehand can help ensure a successful biopsy.
What Should I Pay Attention to After Biopsy?
Post-biopsy considerations for patients may vary depending on the type of biopsy and the organ being treated. In particular, the following may require monitoring and attention for a certain period of time after the biopsy:
- After a lung biopsy: The patient is hospitalized overnight and, in most cases, is monitored for follow-up. Follow-up CT scans may be performed to detect complications such as bleeding or air trapped between the lung membranes. The small bandage applied after the needle is removed can usually be removed after 24 hours. If there are no complications after the procedure, the patient can return to normal daily activities.
- After a kidney biopsy: There is a risk of bleeding after the procedure, and the patient may need to be hospitalized for 24 hours. During this time, the patient may be advised to lie down and not get up. A certain period of time may be required after the procedure before drinking water or eating. Urinalysis and blood tests may be performed, and the patient's blood pressure, pulse, and respiration will be monitored.
- After a liver biopsy: The patient is usually hospitalized overnight. Blood pressure and pulse are checked regularly. Mild pain may occur at the biopsy site for a few hours after the procedure, and medication may be prescribed to manage this. The patient can return to their normal activities after discharge, but it's important not to exert themselves.
- After a thyroid biopsy: The sample is examined by an experienced cytopathologist, and the results are obtained. The results provide information about the nodule's status. Treatment or follow-up is determined based on the results.
- After a breast biopsy: Depending on the procedure, a bandage may be applied. After an open biopsy, stitches may be placed, and mild bruising and soreness may occur at the procedure site. Patients can generally resume their normal lives after the procedure.
It is important for the patient to consult a healthcare professional if any complications or discomfort occur after the biopsy. Contact your doctor immediately, especially if symptoms are unusual or discomfort worsens after the procedure. This is important for the patient's health and recovery.
How is a Lung Biopsy Performed?
A lung biopsy is a procedure used to definitively diagnose conditions such as lung disease or lung cancer. The procedure typically involves identifying the area within the lung where a mass or abnormality is detected.
A lung biopsy typically involves the following steps:
- Preparation: Before the procedure, the patient is properly prepared. The area to be treated is usually numbed with local anesthesia.
- Imaging-guided guidance: The biopsy is performed with the help of imaging techniques such as ultrasound or CT scan. These imaging techniques help the doctor identify the correct area and perform the biopsy with precision.
- Fine-needle aspiration biopsy or core-needle biopsy: Either a fine-needle aspiration biopsy or a core-needle biopsy is typically used during the procedure. A fine-needle aspiration biopsy involves collecting small tissue samples with a thin needle, while a core-needle biopsy allows for the removal of larger pieces of tissue.
- Sample collection during the procedure: The needle is placed in the area under local anesthesia and tissue samples are taken from the mass or abnormal area.
- Control and monitoring: After the procedure, the patient's condition is monitored and necessary checks are performed. In rare cases, complications such as air leaks may occur, which may require intervention.
This procedure is used to make a definitive diagnosis based on the results of samples examined in the pathology laboratory. A lung biopsy is generally carefully planned and performed to ensure patient comfort and safety. After the biopsy, your doctor determines your treatment plan based on the results of the pathological analysis of the samples.
How is a Liver Biopsy Performed?
A liver biopsy is typically performed to diagnose or evaluate various liver diseases. It can be particularly useful in evaluating conditions such as hepatitis, fatty liver, and cirrhosis, as well as to clarify the diagnosis of existing liver masses.
Generally, a liver biopsy takes place as follows:
- Preparation: Before the procedure, the patient may be given a sedative medication intravenously. Therefore, the patient may be asked to fast for 5-6 hours before the procedure.
- During the procedure: The patient lies on their back, and the area to be treated is cleansed in a sterile manner. The area to be treated is determined on the liver, usually using ultrasound or similar imaging techniques.
- Incision and tissue removal: A small incision is made in the affected area, and a needle biopsy is performed to remove a sample of liver tissue. The needle is then directed to the designated area to obtain a tissue sample.
- Observation and monitoring: After the procedure, the patient's condition is monitored and may be kept under observation for a period of time. The patient typically stays in the hospital the same day or overnight and can be discharged the following day.
A liver biopsy results in the analysis of tissue samples taken for pathological examination. These results are used to assess the type, severity, and progression of liver disease or damage. Patients are informed of the potential risks and complications following the biopsy, and necessary precautions are taken.
How is a kidney biopsy performed?
A kidney biopsy is a procedure often performed to diagnose undiagnosed kidney diseases, obtain detailed information about existing disease, or evaluate the condition of a transplanted kidney. The procedure typically takes about half an hour and is performed under local anesthesia.
A kidney biopsy usually takes place as follows:
- Preparation: Before the procedure, the patient is usually prepared by the anesthesiologist for the area where local anesthesia is applied. Before the biopsy, blood tests are usually performed and the patient's condition is assessed.
- Ultrasound- guided needle biopsy: An ultrasound-guided needle biopsy is typically used during the procedure. The kidney is approached using ultrasound guidance, and a small tissue sample is removed with a needle.
- Bleeding risk and observation: There is a risk of bleeding after the biopsy. Therefore, the patient is generally kept under observation for a period of time after the procedure, with follow-up appointments such as urine and blood tests performed for approximately 24 hours. This monitors for potential complications or bleeding risks.
- Follow-up and discharge: At the end of the observation period, if the doctor evaluates and the patient's condition is stable, the patient can be discharged.
Kidney biopsy plays an important role in diagnosing kidney diseases. However, as with any medical procedure, it carries certain risks. Therefore, the patient is monitored and checked as needed before and after the procedure, in accordance with the doctor's instructions.
How is a Breast Biopsy Performed?
A breast biopsy is a procedure performed to examine breast tissue for abnormal findings or a lump. The biopsy typically takes about 15 minutes and can be performed using a variety of methods.
The following methods are generally used when performing a breast biopsy:
- Needle biopsy: A needle biopsy is performed under local anesthesia, guided by ultrasound , MRI, or CT scan. In this procedure, a tissue or fluid sample is removed from the abnormal area with a thin needle. The needle is precisely guided using imaging techniques.
- Vacuum biopsy: Vacuum biopsy is similarly performed under local anesthesia, using imaging guidance. This method uses a specialized device to obtain a larger tissue sample.
- Surgical biopsy: In rare cases, a surgical biopsy may be recommended to evaluate large lesions or certain conditions. In this case, the abnormal area is surgically removed, usually under general anesthesia, and a larger tissue sample is obtained.
The physician determines which biopsy method to use based on the size and location of the abnormal area, as well as other factors. Tissue samples obtained from the biopsy are examined in the pathology laboratory and evaluated by specialists. Side effects such as minimal swelling, bruising, or mild pain may occur after the biopsy, but complications are generally rare. Biopsy results play an important role in the patient's treatment plan.
How Is a Thyroid Biopsy Done? Above Form
A thyroid biopsy is a procedure used to evaluate thyroid nodules. This biopsy is usually performed under ultrasound guidance and local anesthesia.
A thyroid biopsy usually involves the following steps:
- Ultrasound-guided identification: Before the procedure, the nodule(s) in the thyroid area are identified using ultrasound. This is done to determine which nodules may require biopsy.
- Local anesthesia: Local anesthesia is applied to the thyroid area. This numbs the area, making the procedure less uncomfortable.
- Fine-needle aspiration (FNA): A fine-needle aspiration technique is used to obtain cell samples from a nodule. The needle is guided into the nodule using ultrasound guidance, and cell samples are collected. If multiple nodules are present, each nodule can be treated separately.
- Observation and discharge: The procedure is usually completed quickly, and the patient can be observed for approximately half an hour. Patients can usually return to their normal daily activities after the procedure.
A thyroid biopsy is important for determining whether thyroid nodules are benign or malignant. Cell samples are examined in the pathology laboratory, and the results are evaluated. These results play a significant role in determining the patient's treatment plan. Post-biopsy complications are generally rare, and the procedure can generally be a comfortable procedure for the patient.
What are the Types of Biopsies?
A biopsy is a diagnostic procedure that utilizes various methods to remove tissue, cells, or masses from the body. This procedure, which is then examined in the pathology laboratory, plays a crucial role in the diagnosis and treatment of diseases. There are many different biopsy methods:
- Needle biopsy: It is performed in two ways: fine-needle aspiration and core-needle biopsy. Fine-needle aspiration is generally used for areas such as thyroid nodules and prostate, while core-needle biopsy is preferred for obtaining larger tissue samples.
- Open surgical biopsy: This is a procedure, usually performed under general anesthesia, in which the tissue in the suspected area is partially or completely removed.
- Brush biopsy: It is a method performed endoscopy- wise and in which a swab taken from the tissue is examined.
- Chorionic villus biopsy (CVS): It is a biopsy method performed between the 10th and 12th weeks of pregnancy to detect genetic and chromosomal abnormalities of the baby.
- Cone biopsy: It is the procedure of removing cone-shaped tissue from the uterine cervix.
- Endoscopy biopsy: It is a method in which small pieces of tissue are taken using an endoscope.
- Sentinel lymph node biopsy: Used to mark and remove the lymph node where cancer cells have the highest risk of spreading.
- Biopsy by shaving method: It is the process of removing the area under the lesion along with the skin surface.
- Stereotactic biopsy: Used in areas such as the brain and breast. The biopsy site is determined using a CT scan, and the biopsy is performed with a needle or wire.
- Punch biopsy: This is the process of removing a piece of tissue from the skin using a small cutting tool.
- Vacuum biopsy: It is a biopsy method in which tissues are removed by vacuuming.
These and other biopsy methods involve sending tissue samples from the body to a pathology laboratory for analysis. Tissue samples, examined macroscopically and microscopically by expert pathologists, provide crucial information for diagnosing and treating diseases. Regular checkups are essential for a healthy lifestyle.
How Long Does the Biopsy Procedure Take?
The biopsy procedure can vary depending on the method used and the area being biopsied. For example, fine-needle aspiration and core-needle aspiration biopsies can typically be completed in 15 to 20 minutes. Patients can generally resume their daily activities after these procedures.
On the other hand, a vacuum biopsy procedure can take approximately 30 to 40 minutes. After the procedure, the patient may be advised to rest for the day, avoid strenuous activity, and avoid lifting heavy objects.
After a vacuum biopsy, tenderness and bruising can often occur in the area where the tissue was removed. These symptoms are considered part of the normal healing process after the procedure. During this process, the doctor's advice and guidance should be followed. It is important to consult a doctor if you have any concerns or experience an abnormal increase in symptoms. This can be important for the healing process and overall health.
When Will Biopsy Results Be Available?
The time it takes to obtain biopsy results can vary depending on the type of biopsy performed and the workload of the laboratory where the sample will be analyzed. While some results are available immediately after collection, other results may take longer.
Biopsy results taken during surgery are usually reviewed during the surgery itself and are available after the patient wakes up.
However, for most biopsy procedures, results are generally available within a few days to a week. However, in some special cases or those requiring more complex analysis, results may take longer. Factors such as the laboratory's workload and the need to send the sample may also influence this process. Your physician or healthcare professional can provide more information about specific conditions or biopsy results.
Biopsy results vary depending on the workload of the laboratory where the samples will be analyzed, the type of sample being analyzed, and its complexity. While some results are available quickly after the cell or tissue sample is collected, other results may take several days, a week, or even longer.
Biopsy results taken during surgery are usually examined during the surgery and can be evaluated after the patient wakes up.
In most cases, biopsy results are available within a few days to a week. However, in some cases, results may take longer, particularly if complex analyses are required or specialized testing is required to examine the tissue samples. The time it takes to receive results depends on the sample being sent to the laboratory and the methods used to analyze it. Your doctor can provide more information about the process for analyzing your samples.

